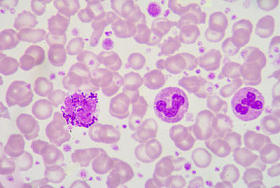
中性粒细胞及嗜碱性粒细胞

中性抽象艺术画
图片基本信息
图片ID:26484
图片大小:8.77MB
图片尺寸:3227 x 4156 像素
颜色模式:RGB
文件格式:JPG
推荐软件:PS,AI
用途:概念抽象
构图:竖图
版权说明:如需购买商用授权,请购买企业VIP
授权对象:企业,个人
图司机为设计师提供高清中性抽象艺术画图片版权下载,图片为概念抽象,大小为8.77MB,尺寸为3227 x 4156px,更多关于蓝色,背景,绘画,装饰,艺术,摘要,棕色,黑色,仿古,近代,办公室,绘,浅驼色,首页,时尚,行,灰色,画廊,图稿,画布,压克力,当代,最受欢迎,正方形,室内设计图,抽象艺术,墙 装饰商用高清版权图片,快来图司机免费下载吧。